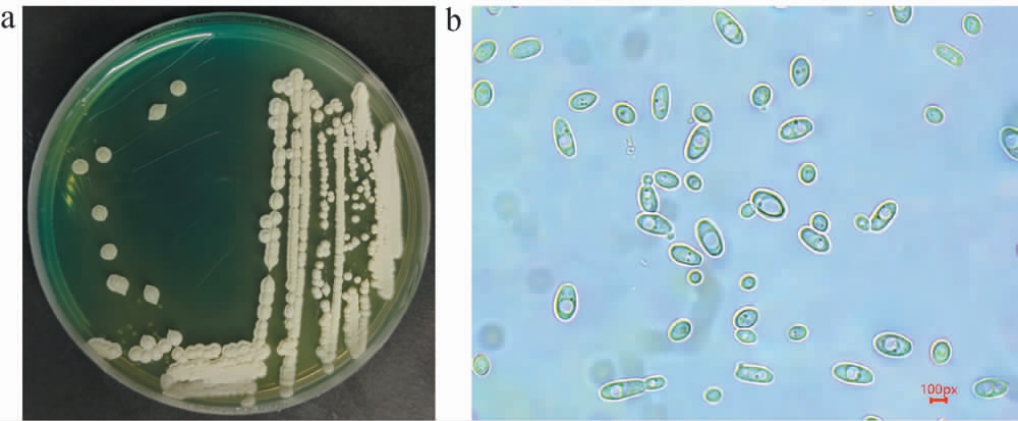

红枣(Ziziphus jujuba Mill.)又名大枣,是鼠李科(Rhamnaceae)枣属(Ziziphus)植物的果实[1]。 中国枣树种植面积在全球占比超98%[2],其中,新疆是最大产区[3]。阿拉尔红枣优势明显,其产业已成为当地农业经济支柱[4]。 然而,近年来随着红枣产量的急剧增加,市场价格出现了大幅下跌的趋势[5]。面对这一挑战,酿酒产业的发展为红枣提供了新的出路。果酒作为酒类市场的一个重要发展方向,其市场前景日益广阔[6]。将红枣用于酿酒,不仅能有效解决鲜枣不耐贮藏、易腐烂的问题,延伸红枣产业链条,还可拓宽农户增收渠道,为推动乡村振兴战略的实施提供助力[7]。 此外,红枣酿酒在保留其原有营养成分的基础上,显著提升了产品的经济附加值[8],实现了从初级农产品到高附加值加工品的转化。
酵母在酿造过程中对果酒的风味起着至关重要的作用,不同种类的酵母则会对果酒产生不同的影响[9]。新疆本土酵母因新疆独特的气候条件,如较大的昼夜温差、干燥的空气等,在性能上具有较强的适应性,能够更好地应对复杂的环境变化。 在发酵方面,新疆本土酵母具有独特的代谢特性,可以赋予食物特别的风味特征,如在新疆传统的馕制作中,本土酵母使馕具有独特的风味和口感[10]。 从资源可持续性来说,本土酵母资源是新疆的特色资源,对其深入研究和利用有利于推动新疆本地特色食品产业的可持续发展。 近年来,有诸多研究表明,非酿酒酵母(non-Saccharomyces)可以增强果酒的风味和香气。 如BAO Y R等[11]研究发现,与酿酒酵母(Saccharomyces cerevisiae)相比,利用巴斯德毕赤酵母(Pichia pastoris)发酵芒果汁,苯乙醇和乙酸乙酯含量更高,具有更加浓郁的花香和果香;CAO K X等[12]从传统发酵食品中分离筛选出28株产香非酿酒酵母,并将其用于啤酒酿造,结果表明,不同种类的非酿酒酵母对啤酒香气有独特的影响。 因此,将新疆本土非酿酒酵母与红枣发酵酒相结合,尝试解决目前红枣酒所存在的风味淡、典型性模糊[7]等突出问题具有一定的研究价值。
本研究以采集自红枣果园的土壤为分离源,采用传统培养分离法结合嗅闻法从红枣果园土壤中分离筛选产香酵母菌株。进一步利用筛选得到的产香酵母发酵红枣清汁,通过顶空固相微萃取-气相色谱-质谱(headspace solid-phase microextraction-gas chromatography-mass spectrometry,HSSPME-GC-MS)检测发酵液中的挥发性风味物质,筛选优良的产香酵母菌株。最后通过形态学观察及分子生物学技术对优良产香酵母菌株进行鉴定,并对其产气能力及耐受性进行分析,以期提高红枣酒的品质,为南疆红枣酒专用酵母的开发奠定基础。
1 材料与方法
1.1 材料与试剂
1.1.1 样品与菌种
土壤:新疆阿拉尔市绿园镇红枣果园;干灰枣:新疆阿拉尔市绿园镇;果酒专用酵母SY:安琪酵母股份有限公司。
1.1.2 试剂
葡萄糖、氯化钠、硫酸镁(均为分析纯):福晨(天津)化学试剂有限公司;柠檬酸(分析纯):山东英轩实业股份有限公司;胰蛋白胨、酵母浸粉、琼脂粉、蛋白胨(均为生化试剂):北京奥博星生物技术有限责任公司;溴甲酚绿、硫酸锰、氯化铁、氯化钙、磷酸二氢钾、氢氧化钠、氯化钙、硫酸亚铁、氯化钾(均为分析纯):天津市鑫铂特化工有限公司;无水乙醇(分析纯):天津市致远化学试剂有限公司;环己酮(分析纯):北京索莱宝科技有限公司;酵母基因组脱氧核糖核酸(deoxyribonucleic acid,DNA)提取试剂盒:天根生化科技(北京)有限公司。其他试剂均为国产分析纯。
1.1.3 培养基
酵母浸出粉胨葡萄糖(yeast extract peptone dextrose,YPD)固体培养基[13]:葡萄糖20 g,酵母浸粉10 g,蛋白胨20 g,琼脂粉20 g,蒸馏水定容至1 000 mL,121 ℃高压蒸汽灭菌20 min。YPD液体培养基:YPD固体培养基中不添加琼脂。
WL培养基[14]:酵母浸粉4 g、胰蛋白胨5 g、葡萄糖50 g、磷酸二氢钾0.55 g、氯化钾0.425 g、氯化钙0.125 g、硫酸镁0.125 g、氯化铁0.002 5 g、硫酸锰0.002 5 g、溴甲酚绿22 mg、琼脂粉20 g,蒸馏水定容至1 000 mL,调整pH值为6.5,121 ℃高压蒸汽灭菌120 min。
产香培养基[15]:黄豆粉水解液50 mL(称取黄豆粉5 g,加入50 mL 0.1 mol/L盐酸溶液于40 ℃水浴水解1.5 h,再用0.1 mol/L氢氧化钠溶液调pH至6.0,用纱布过滤,取滤汁加水至50 mL)、葡萄糖100 g、氯化钙2.5 g,硫酸镁2.5 g,氯化钠2.5 g,硫酸亚铁2.5 g,氯化钾2.5 g,蒸馏水定容至1 000 mL。121 ℃高压蒸汽灭菌120 min。
1.2 仪器与设备
LE203E/02电子天平:梅特勒-托利多(上海)有限公司;HH-501超级恒温水浴锅:江苏金怡仪器科技有限公司;SW-CJ-2FD超净工作台:上海博讯实业有限公司医疗设备厂;DNP-9082型电热恒温培养箱:冠森生物科技(上海)有限公司;LDZF-50KB-II立式压力蒸汽灭菌锅:上海申安医疗器械厂;7890B-7000D气相色谱-质谱联用仪:美国安捷伦公司;SAAB-57328U SPME手动进样柄、50/30 μm DVB/CAR/PDMS手动萃取头:上海安谱实验科技股份有限公司;TGL-16G台式离心机:上海菲恰尔分析仪器有限公司;HT118ATC手持折光仪:禹城市田园信科光学仪器有限公司。
1.3 方法
1.3.1 酵母菌的富集、分离及纯化
取10 g土壤样品,加入盛有50 mL无菌水的锥形瓶中,摇匀制成菌悬液;取10 mL菌悬液加入到含200 mL红枣浆(取适量红枣去核放入榨汁机中,加入与红枣齐平的蒸馏水,打浆)的250 mL锥形瓶中,用封口膜封住瓶口,在自然条件下富集培养2 d。 用无菌水将富集菌悬液按10倍梯度稀释至10-6,取不同梯度的稀释液100 μL分别涂布于YPD固体培养基上,28 ℃培养48 h,挑选出具有酵母菌菌落形态的单菌落分离纯化2~3次,得到单菌落。
1.3.2 产香酵母的筛选
将分离纯化后的单酵母菌落接种于产香培养基中,于28 ℃、150 r/min条件下摇床培养7 d,采用嗅闻法筛选出具有明显香气或特殊香气、无不良气味的菌株,进行编号并记录。
1.3.3 产香酵母发酵红枣清汁
将初筛得到的酵母菌株接种于YPD液体培养基中,于28 ℃、150 r/min条件下培养48 h,作为种子液。参考尹蓉等[16]的方法制备红枣清汁,将种子液按1%(V/V)的接种量接种于红枣清汁中,以未接种的红枣清汁(QZ)以及接种果酒专用酵母SY发酵的红枣清汁作为对照,20 ℃密闭发酵20 d[16]。采用HS-SPME-GC-MS技术测定挥发性风味成分[17],筛选优良的产香酵母。
1.3.4 优良产香酵母菌的鉴定
形态学观察:将筛选得到的优良产香酵母划线接种于WL培养基,于28 ℃条件下培养48 h,观察记录菌落形态,并取样制片,在显微镜中观察记录细胞形态。
分子生物学鉴定:将筛选得到的优良产香酵母接种至YPD液体培养基,28 ℃、150 r/min条件下振荡培养48 h,采用真菌基因组DNA提取试剂盒提取菌株基因组DNA,以其为模板,采用通用引物NL1(5'-GCATATCAATAAGCGGAGGAAAAG-3')和NL4(5'-GGTCCGTTTCAAGACGG-3')PCR扩增26S rDNA D1/D2区基因序列[18],PCR扩增产物经1%琼脂糖凝胶电泳检测合格后,委托北京三博远志生物公司进行测序。将测序结果提交至美国国家生物技术信息中心(National Center of Biotechnology Information,NCBI)的GenBank数据库中采用基本局部比对搜索工具(basic local alignment search tool,BLAST)进行同源性比对。 选取同源性较高的模式菌株的26S rDNA基因序列,采用MEGA6.0软件中的邻接法(neighbor-joining,NJ)构建系统发育树。
1.3.5 优良产香酵母的产气能力测定
以果酒专用酵母SY为对照,采用杜氏小管法测定优良产香酵母菌株的产气能力[19]。
1.3.6 优良产香酵母的耐受性分析
将优良产香酵母菌株按2%(V/V)的接种量分别接种于含有不同质量浓度的柠檬酸(15 g/L、18 g/L、21 g/L、24 g/L、27 g/L)[20]、葡萄糖(200 g/L、250 g/L、300 g/L、350 g/L、400 g/L)及不同体积分数乙醇(4%、8%、12%、16%、20%)的YPD液体培养基中,于28 ℃条件下静置培养24 h[21],测定OD600 nm值,重复3次。以果酒专用酵母SY为对照,考察筛选菌株对柠檬酸、葡萄糖及乙醇的耐受性。
1.3.7 数据处理
所有试验重复3次,结果以“平均值±标准差”表示,利用Origin 2024处理数据并绘图。
2 结果与分析
2.1 产香酵母的分离纯化及筛选
从土壤中共分离纯化得到43株酵母菌菌株,进一步通过嗅闻法从中筛选得到4株具有明显酒香和特殊香气的酵母菌株,编号分别为F4、F21、F29和F30,结果见表1。由表1可知,菌株F4发酵液呈浓郁的甜香和酒香,菌株F21发酵液呈浓郁的果香、花香和酒香,菌株F29发酵液呈较浓的果香和甜香,菌株F30发酵液呈清新的果香和较浓的酒香。
表1 产香酵母菌株的嗅闻结果
Table 1 Olfactory results of aroma-producing yeast strains

注:“+”越多表示香气越浓。
菌株编号香气描述香味浓烈程度F4 F21 F29 F30甜香和酒香浓郁果香、花香和酒香浓郁果香和甜香较浓清新果香和酒香较浓+++++++++++++++
2.2 产香酵母发酵红枣清汁
2.2.1 挥发性风味成分分析
以红枣清汁(QZ)及果酒专用酵母SY发酵红枣清汁为对照,采用菌株F4、F21、F29、F30发酵红枣清汁,并采用HS-SPME-GC-MS测定发酵液中的挥发性香气成分,结果见表2。
表2 红枣清汁发酵液和红枣清汁挥发性风味物质含量GC-MS分析结果及香气描述
Table 2 Results of volatile flavor substances contents in fermented clear jujube liquid and clear jujube juice analyzed by GC-MS and aroma description

种类 序号化合物香气描述醇类(21种)1234567891 0 11 12 13 14 15苯乙醇异戊醇正壬醇正己醇苯甲醇正辛醇环辛醇正庚醇异丁醇蘑菇醇仲辛醇3-辛醇苏合香醇α-松油醇2-乙基己醇玫瑰香白兰地,草香玫瑰香果香,生青味甜香,果香柑橘香樟脑气味芳香味指甲油味药草香,薰衣草香芳香气味壤香、蘑菇、霉香、蜡香,并带有木香、辛香和薄荷香花香花香花香含量/(μg·L-1)F4F21F29F30SYQZ 4 315.10±56.00 39.40±3.50 2.10±2.10--61.20±4.20----4.90±0.50 2.80±0.90 3.10±1.20 1.80±1.60------4.10±2.00 256.20±8.90 10.10±7.90--------------13.10±0.90--2.10±0.90--1.30±2.30 4.30±2.80 388.70±18.90------32.20±6.70--------------------3 455.20±312.00--------------5.10±8.80--1.40±2.40--233.20±12.50----192.10±38.60------10.00±0.70------3.10±3.10----------------4.10±7.10 8.10±14.00--5.20±5.20 3.20±0.40 4.10±0.40--23.20±0.70----27.10±12.20 2.10±3.60--
续表

种类 序号化合物香气描述含量/(μg·L-1)F4F21F29F30SYQZ 16 17 18 19 20 21强烈的油脂气味,柑橘和玫瑰气味,青香,果香芳香气味柑橘香溶剂气味具有清新、果香和花香的气味薄荷气味酯类(25种)22 23 24 25 26 27 28 29 30 31 32 33 34 35 36 37 38 39 40 41 42 43 44 45 46果香果香,菠萝香果香,菠萝香香蕉香花香,玫瑰香果香依兰香,果香洋葱、大蒜、萝卜样香气芳香味呈桃、椰子似甜果香气和燕麦面包香味温和气味蜜香、玫瑰香和果香冬青油气味相似芳香味温和气味果香果香果香果香,酒香柠檬、薰衣草香甜香,玫瑰香,桃香菠萝香混合了果香、酒香、甜味和辛辣感的复杂芳香果香茉莉花香酸类(10种)47 48 49 50 51 52 53 54 55 56 4-甲基-1-己醇3-甲基-3-戊醇反式-2-辛烯-1-醇五甲基乙醇S(-)-2-甲基-1-丁醇新戊醇小计乙酸乙酯己酸乙酯辛酸乙酯乙酸异戊酯3-苯丙酸乙酯戊酸乙酯安息香酸乙酯硫代乙酸甲酯扁桃酸乙酯丙位辛内酯乳酸丙酯苯乙酸乙酯乙酰水杨酸甲酯甲酸甲酯碳酸二乙酯苯甲酰甲酸乙酯2-丁酮酸乙酯2-甲基丙酸丙酯癸酸乙酯(±)-α-乙酸松油酯乙酸苯乙酯庚酸乙酯甲酸乙酯1-甲基乙酸丁酯乙酸苄酯小计丁酸乙酸己酸庚酸正癸酸正戊酸正辛酸2-辛烯酸苯基丁二酸正壬酸小计类汗味辛辣味类汗味脂肪香柑橘香刺激性气味奶酪香奶酪香甜香微弱的油脂气味3.70±0.60------29.10±7.90--4 467.30±39.90 55.70±8.10 54.80±7.70 243.10±18.60 4.10±4.10 65.60±11.90--166.90±38.30------1.20±2.10--6.90±0.50----------369.10±27.90--523.70±7.50 26.20±0.70 3.80±0.30 5.90±1.10 1.10±1.00 1 528.10±39.90 517.10±56.90 1 417.20±33.90 76.10±0.80 80.60±11.60--38.70±18.90 513.06±0.90--24.10±1.30 6.10±2.30 2 673.50±30.30--6.20±4.50--1.20±2.10----294.50±17.90 6.20±3.80 13.10±1.60 3.40±1.80 4.90±1.90 18.20±1.80--45.10±1.80----6.90±1.80--18.30±1.50--12.30±1.80------2.80±1.60----43.00±21.70--------174.20±35.10--323.20±13.00 219.30±14.70 69.20±14.90 13.20±0.50 14.90±3.60 72.60±14.90 3.40±3.00----715.80±72.40----------7.30±12.60 428.20±13.00 103.10±34.10 35.30±30.60 31.40±30.10 8.90±15.40 26.80±46.40--48.30±1.60----------------------323.20±11.50--656.10±21.10 23.10±12.10------1 256.20±71.70 15.20±14.70 186.30±18.00--15.60±14.00--78.60±16.10 104.50±14.00------400.20±70.10--------5.30±9.20--3 700.20±291.90 65.00±23.90 196.90±22.50 492.10±22.90 14.00±12.90 187.20±22.90 1.30±2.30 192.00±22.90----------------------197.20±54.20--94.00±50.30--------1 439.70±118.00 29.30±2.30----26.50±45.90--352.40±31.20 516.60±30.20------924.80±79.30------------205.20±36.20 27.20±3.70 31.80±4.30 258.00±4.70 2.90±2.90----106.10±16.80 29.20±12.80 23.10±19.80----------456.70±8.80 5.00±8.70 114.20±10.10--178.20±11.10--121.70±11.10--------1 354.10±36.50 52.20±20.10 113.60±28.10--9.20±15.90--64.60±13.30 91.90±13.80------331.50±8.00----3.20±0.10------80.30±20.10--6.90±1.70 7.00±0.70------4.30±7.40----5.30±4.70-------------------2.00±3.50----------25.50±3.60 14.40±25.00--90.90±20.20--28.40±11.30 75.80±3.40 36.90±0.90------246.40±14.50
续表

注:香气描述词参考在线风味数据库(http://www.flavornet.org/index.html),“--”表示未检测出。
醛酮类(13种)种类 序号化合物香气描述57 58 59 60 61 62 63 64 65 66 67 68 69玫瑰香舒适气味刺激性气味杏仁香蕉香果香、青香、蜡香、蔬菜香、蘑菇香、干酪香果香椰子香玫瑰香辛辣味苦杏仁香杏仁和山楂花香气风信子香奶油香酚类(2种)70 71大马酮环丁酮羟乙醛糠醛3-辛酮正辛醛椰子醛大马士酮乙缩醛苯甲醛苯乙酮苯乙醛3-羟基-2-丁酮小计对甲酚2,4-二叔丁基酚酚类物质总和总和芳香气味刺激性气味含量/(μg·L-1)F4F21F29F30SYQZ 35.40±1.90 54.80±2.00--------9.40±1.00----42.10±1.10 2.00±1.10----143.70±1.20--565.40±22.80 565.40±22.80 9 378.00±13.80--9.40±5.00--------7.90±1.60 19.40±2.00--12.10±3.40 2.30±0.90----51.10±7.90--606.70±23.80 606.70±23.80 1 797.70±122.20--------------63.30±8.80------2.30±4.00 29.40±5.50 95.00±5.10------2 179.60±113.30------------------------------498.90±19.90 498.90±19.90 6 563.60±178.20----5.40±4.90----------3.10±5.40 53.60±53.60------62.10±54.40--778.80±101.30 778.80±101.30 2 731.70±49.50------4.30±4.20 2.10±1.20 1.20±1.20------14.20±6.60------21.80±1.00 1.20±2.10 565.70±12.80 566.90±12.80 940.90±29.00
由表2可知,从样品中共检测出71种挥发性风味物质,包括醇类21种、酯类25种、酸类10种、醛酮类13种、酚类2种。红枣清汁中共检测出25种挥发性风味物质,包括醇类9种、酯类5种、酸类5种、醛酮类4种、酚类2种;菌株SY红枣发酵液中共检测出24种挥发性风味物质,包括醇类3种、酯类12种、酸类5种、醛酮类3种、酚类1种;菌株F4红枣发酵液中共检测出39种挥发性风味物质,包括醇类11种、酯类14种、酸类8种、醛酮类5种、酚类1种;菌株F21红枣发酵液中共检测出32种挥发性风味物质,包括醇类8种、酯类11种、酸类7种、醛酮类5种、酚类1种;菌株F29红枣发酵液中共检测出20种挥发性风味物质,包括醇类3种、酯类9种、酸类5种、醛酮类3种;菌株F30红枣发酵液中共检测出19种挥发性风味物质,包括醇类5种、酯类9种、酸类4种、酚类1种;综上,菌株F4红枣发酵液中的挥发性风味物质种类及含量最高,确定其为优良的产香酵母菌株。
菌株F4红枣发酵液中酯类物质总含量为1 528.1 μg/L,比菌株SY红枣发酵液高12.85%,所含有的酯类物质种类和含量上差距并不明显;与红枣清汁相比,酯类物质含量提高5 892.55%,种类也明显增多,包括乙酸乙酯、乙酸异戊酯、3-苯丙酸乙酯、乳酸丙酯、乙酰水杨酸甲酯、癸酸乙酯、乙酸苯乙酯、庚酸乙酯、甲酸乙酯、1-甲基乙酸丁酯、乙酸苄酯,这些酯类物质均为菌株F4红枣发酵液中独有的挥发性风味物质,可赋予枣酒果香和花香[22-23]。 结果表明,菌株F4具有高产乙酯类物质的特征,在与酯类物质相关方面的研究具有较强的潜在应用价值。
菌株F4红枣发酵液中醇类物质总含量为4 467.3 μg/L,比菌株SY红枣发酵液及红枣清汁分别高2077.05%、5463.26%,其中异戊醇、仲辛醇、2-乙基己醇、4-甲基-1-己醇、S(-)-2-甲基-1-丁醇为其独有的挥发性风味物质,异戊醇具有青苹果白兰地香气,且能衬托酯香,赋予枣酒特有的香味[24-25]。
在果酒的发酵过程中,酸类物质由醇类的氧化或酵母的代谢活动形成,具有奶酪和脂肪香气,可以增加枣酒香气的复杂度[21-26]。 与菌株SY红枣发酵液及红枣清汁相比,菌株F4红枣发酵液中的的丁酸、乙酸、庚酸、正辛酸、苯基丁二酸、正壬酸含量较高,赋予了枣酒更有层次的风味。然而醛酮类和酚类物质含量虽然较少,但对果酒的香气也起到十分重要的作用[27],与菌株SY红枣发酵液及红枣清汁相比,大马酮和环丁酮是菌株F4红枣发酵液独有的挥发性风味物质,其中大马酮具有浓烈的玫瑰香气[28],是赋予果酒风味的主要成分[29]。 综上,从强化枣酒香气复杂度与塑造独特风味的角度来看,菌株F4是酿造高品质红枣酒的更优菌株选择。
2.2.2 风味轮廓分析
为了更直观、系统地比较菌株F4红枣发酵液与红枣清汁、菌株SY红枣发酵液的香气差异,进一步依据检出的香味物质成分的含量,对菌株F4红枣发酵液、菌株SY红枣发酵液和红枣清汁的香气进行划分,并以各类香气的含量绘制风味轮廓雷达图,结果见图1。由图1可知,与红枣清汁及菌株SY红枣发酵液相比,菌株F4红枣发酵液的各类香气均有明显增强,尤其增强了花香风味,果香和刺激性气味也有明显增强。

图1 红枣发酵液及红枣清汁的风味轮廓雷达图
Fig. 1 Radar map of flavor profile of fermented jujube liquid and clear jujube juice
2.3 优良产香酵母F4的鉴定
2.3.1 形态学观察
优良产香酵母F4在WL培养基上的菌落及细胞形态见图2。由图2可知,菌株F4的菌落呈圆形,乳白色,有绒毛感,边缘不整齐;细胞形态均为椭圆形。初步鉴定菌株F4为酵母菌。
图2 优良产香酵母F4的菌落(a)及细胞(b)形态
Fig. 2 Colony (a) and cell (b) morphology of excellent aromaproducing yeast F4
2.3.2 分子生物学鉴定
基于26S rDNA D1/D2区基因序列,构建菌株F4的系统发育树,结果见图3。由图3可知,菌株F4与库德里阿兹威毕赤酵母(Pichia kudriavzevii)聚于一支,亲缘关系最近,相似度为100%,结合形态学特征,最终鉴定菌株F4为库德里阿兹威毕赤酵母(Pichia kudriavzevii)。

图3 基于26S rDNA D1/D2区基因序列菌株F4的系统发育树
Fig. 3 Phylogenetic tree of strain F4 based on the 26S rDNA D1/D2 gene sequence
2.4 库德里阿兹威毕赤酵母F4的产气能力分析
酵母菌的产气性能是其重要的生理特性之一,直接影响果酒的风味及发酵效率。因此,通过观察杜氏小管内产生的气泡时间和体积测定库德里阿兹威毕赤酵母F4的产气能力,结果见表3。
表3 库德里阿兹威毕赤酵母F4与菌株SY的产气情况
Table 3 Gas production of Pichia kudriavzevii F4 and strain SY

注:“+”表示产气量为1/4杜氏小管;“++”表示产气量为1/2杜氏小管;“+++”表示产气量为3/4杜氏小管;“++++”表示产气量充满整个杜氏小管。
培养时间/h菌株F4菌株SY 24 48 72++++++++++++++
由表3可知,库德里阿兹威毕赤酵母F4和菌株SY在杜氏小管中均有气体产生,但是库德里阿兹威毕赤酵母F4的产气量高于菌株SY。培养48 h时,菌株F4产生的气体已经充满杜氏小管,漂浮在液体培养基上,而对照组菌株SY产生的气体仅占杜氏小管的1/2。综上,库德里阿兹威毕赤酵母F4具有较好的产气能力。
2.5 库德里阿兹威毕赤酵母F4的耐受性分析
2.5.1 乙醇耐受性分析
乙醇是酵母菌发酵产生的主要副产物,浓度过高会胁迫酵母菌的生长[30]。因此,考察库德里阿兹威毕赤酵母F4和菌株SY的乙醇耐受性,结果见图4。

图4 不同乙醇体积分数对库德里阿兹威毕赤酵母F4和菌株SY生长的影响
Fig. 4 Effects of different ethanol volume fraction on the growth of Pichia kudriavzevii F4 and strain SY
由图4可知,当乙醇体积分数<12%时,随着乙醇体积分数的升高,菌株F4的生长无明显变化,而菌株SY的OD600 nm值升高;当乙醇体积分数>12%之后,菌株F4和SY的生长均受到抑制,但均可在乙醇体积分数为20%的条件下生长。此外,不同乙醇体积分数下,菌株SY的OD600 nm值均高于菌株F4,说明菌株F4对乙醇的耐受性弱于菌株SY,这与冯军等[31]的研究结果一致。 果酒发酵时酒精度一般在7%vol~13%vol[32],因此,菌株F4作为果酒发酵菌株,可以基本满足发酵要求。
2.5.2 酸耐受性分析
环境中的酸度对酵母菌的生长也有着重要影响,因此,考察库德里阿兹威毕赤酵母F4和菌株SY的耐酸性,结果见图5。

图5 不同柠檬酸质量浓度对库德里阿兹威毕赤酵母F4和菌株SY生长的影响
Fig. 5 Effects of different mass concentration of citric acid on the growth of Pichia kudriavzevii F4 and strain SY
由图5可知,随着柠檬酸质量浓度的升高,菌株F4和SY的OD600nm值均呈先升高后下降的趋势,均在柠檬酸质量浓度为27 g/L的条件下生长。此外,不同柠檬酸质量浓度条件下,菌株SY的OD600 nm值均高于菌株F4,说明菌株F4对柠檬酸的耐受性弱于菌株SY,这可能会导致果酒出现酒精生产率低,发酵周期延长等问题[33]。
2.5.3 葡萄糖耐受性分析
在果酒酿造过程中通常需要添加一定量的葡萄糖,葡萄糖的质量浓度是影响酵母菌生长状态的关键因素。葡萄糖质量浓度较低时能促进酵母菌生长,但其质量浓度过高会造成高渗透压环境,对酵母菌的生长产生抑制作用[34]。因此,在果酒的高糖基质的发酵过程中,筛选具有强耐高渗能力的酵母菌菌株,是保障发酵顺利进行、提升产品品质的关键前提之一。因此,考察库德里阿兹威毕赤酵母F4和菌株SY的葡萄糖耐受性,结果见图6。

图6 不同葡萄糖质量浓度对库德里阿兹威毕赤酵母F4和菌株SY生长的影响
Fig. 6 Effects of different mass concentration of glucose on the growth of Pichia kudriavzevii F4 and strain SY
由图6可知,随着葡萄糖质量浓度的升高,菌株F4和SY的OD600nm值均呈下降趋势,说明两株菌的生长均受到明显抑制,但均可在葡萄糖质量浓度400 g/L的条件下生长。此外,不同葡萄糖质量浓度条件下,菌株SY的OD600 nm值均高于菌株F4,说明菌株F4对葡萄糖的耐受性弱于菌株SY,这与葛佳伟等[33]的研究结果一致。
3 结论
本研究从红枣果园土壤样品中分离纯化获得43株酵母菌株,通过嗅闻法初筛得到4株产香酵母菌株。 将这4株菌株分别应用于发酵红枣清汁,最终筛选鉴定得到库德里阿兹威毕赤酵母(Pichia kudriavzevii)F4为优良的产香菌株。菌株F4红枣发酵液花果香风味明显增强,从中共检出39种挥发性风味物质,其中21种为区别于果酒专用酵母SY红枣发酵液的独有成分,26种为红枣清汁中未检出的新成分。菌株F4具有较好的产气能力和耐受性,可在48 h内产气量充满整个杜氏小管,且可耐受乙醇体积分数20%、柠檬酸质量浓度27 g/L和葡萄糖质量浓度400 g/L。综上,菌株F4具备在红枣酒酿造中应用的潜力,可尝试将其与酿酒酵母进行混合发酵应用,有望在保留红枣原有风味特征的基础上,显著提升红枣酒的香气浓郁度与风味复杂度,从而改善红枣酒的整体品质。
[1] LU Y,BAO T,MO J L,et al.Research advances in bioactive components and health benefits of jujube(Ziziphus jujuba Mill.) fruit[J] . J Zhejiang Univ Sci B,2021,22(6):431-449.
[2] 靳娟,李丽莉,杨磊,等.新疆红枣产业发展现状分析[J] .新疆农业科学,2024,61(S1):106-110.
[3] 彭程晨.新疆红枣产区质量评价与管理平台研发应用[D] .石河子:石河子大学,2024.
[4] 尹家彬. 乡村振兴背景下新疆阿拉尔红枣产业发展研究[D] . 塔里木:塔里木大学,2022.
[5] 原洪,姜敏,路亚龙. 红枣发酵产品的研究进展[J] . 食品科技,2024,49(5):83-90.
[6] 郭慧静,金新文,沈从举,等. 新疆红枣产业现状及前景展望[J] . 华中农业大学学报,2023,42(5):35-41.
[7] 魏昭,靳雅楠,王权,等.发酵枣酒研究现状及前景展望[J] .食品与发酵科技,2025,61(2):112-117.
[8] 李安平,丁彦鹏,陈建华,等. 红枣果酒苦味来源及成分分析[J] . 中国食品学报,2013,13(7):236-241.
[9] WANG X L,LIU X T,LONG J Q,et al.Isolation,screening,and application of aroma-producing yeast for red dragon fruit wine[J] .Food Biosci,2024,59:103878.
[10] 于静,许倩,李芬,等. 新疆7地区馕用酸面团微生物多样性分析[J] .食品研究与开发,2023,44(2):183-189.
[11] BAO Y R,ZHANG M,CHEN W X,et al.Screening and evaluation of suitable non-Saccharomyces yeast for aroma improvement of fermented mango juice[J] .Food Biosci,2021,44:101414.
[12] CAO K X,WU J R,WAN X J,et al.Impact of non-Saccharomyces yeasts derived from traditional fermented foods on beer aroma:Analysis based on HS-SPME-GC/MS combined with chemometrics[J] . Food Res Int,2024,187:114366.
[13] 潘冬梅,杨传伦,张心青,等. 响应面法优化酿酒酵母培养基[J] . 中国酿造,2024,43(6):206-212.
[14] 刘飞,姜蕾,丁真真,等. 发酵驴乳中酵母菌的分离鉴定及发酵特性研究[J] .中国调味品,2023,48(12):75-78,97.
[15] 韩志双,刘军,原海兵,等. 一株产香酵母发酵条件优化及应用于发酵豆瓣酱的研究[J] .中国调味品,2013,38(12):14-18.
[16] 尹蓉,张倩茹,王俊宇,等.13个品种红枣发酵酒的品质差异分析[J] .食品工业科技,2023,44(5):277-284.
[17] ZHANG J,HE Y G,YIN L G,et al.Isolation of aroma-producing Wickerhamomyces anomalus yeast and analysis of its typical flavoring metabolites[J] .Foods,2023,12(15):2934.
[18] 郭冬琴. 橙汁中酵母菌的分离鉴定及其快速分子检测技术研究[D] .重庆:西南大学,2012.
[19] 吴锐佳,王雨辰,黄先敏,等.咖啡果优良本土酵母菌筛选及发酵特性[J] .食品研究与开发,2024,45(22):202-211.
[20] 顾桁浩,王宇,缪嘉鑫,等. 百香果果酒酿造中产酯酿酒酵母的筛选、鉴定及其发酵特性研究[J] .食品与发酵工业,2025,51(17):159-167.
[21] 张小勤,潘晓姗,李东,等.贵州产地刺梨果酒产酒精酵母的筛选及其发酵性能研究[J] .中国酿造,2022,41(12):97-102.
[22] 彭璐,明红梅,陶敏,等.樱桃酒酿造用产香酵母的筛选及其特征香气成分分析[J] .中国酿造,2020,39(11):36-42.
[23] 安琪,张霞,郭玉琪,等.发酵方式对苹果幼果果酒品质及香气成分的影响[J] .中国食品学报,2025,25(1):335-347.
[24] 杜亚军,郭尚,李群,等. 木枣产香酵母的分离筛选和应用[J] . 中国酿造,2021,40(10):123-128.
[25] 田晓彩,尹蓉,张倩茹,等. 不同品种红枣发酵酒有机酸及香气成分分析[J] .食品科技,2022,47(9):257-263.
[26] LIU W H, JI R J, AIMAIER A, et al. Adjustment of impact phenolic compounds, antioxidant activity and aroma profile in Cabernet Sauvignon wine by mixed fermentation of Pichia kudriavzevii and Saccharomyces cerevisiae[J] .Food Chem X,2023,18:100685.
[27] 钟轲,肖建,汤晓宏,等. 非酿酒酵母对脐橙果酒品质的影响[J] . 中国酿造,2025,44(1):148-155.
[28] 校诺娅. 水分胁迫对‘玫瑰香’葡萄果实挥发性化合物及相关基因表达的影响[D] .银川:宁夏大学,2020.
[29] 赵岩,马艳蕊,李学震,等. 不同发酵条件对枣酒风味的偏向性差异分析[J] .食品科技,2023,48(4):75-83.
[30] 黄倩,蔡建,高秀,等. 羊奶果果酒专用本土非酿酒酵母的筛选、鉴定及特性研究[J] .中国酿造,2024,43(6):156-161.
[31] 冯军,冯晓红,李可,等.酵母及其衍生物在果酒酿造中的特性及应用进展[J] .中国酿造,2025,44(1):26-34.
[32] 边名鸿,许强,周阳子,等. 桑葚酒用非酿酒酵母的筛选及特性研究[J] .中国酿造,2021,40(5):70-75.
[33] 葛佳伟,郭琪,罗娜,等. 啤酒酿造用非酿酒酵母性能测试及其发酵特性研究[J] .食品与发酵工业,2025,8(14):1-16.
[34] 尹欣,杨媛媛,闫卓洋,等. 酸樱桃果酒专用酵母菌的筛选、鉴定及耐受性研究[J] .中国酿造,2025,44(5):86-91.